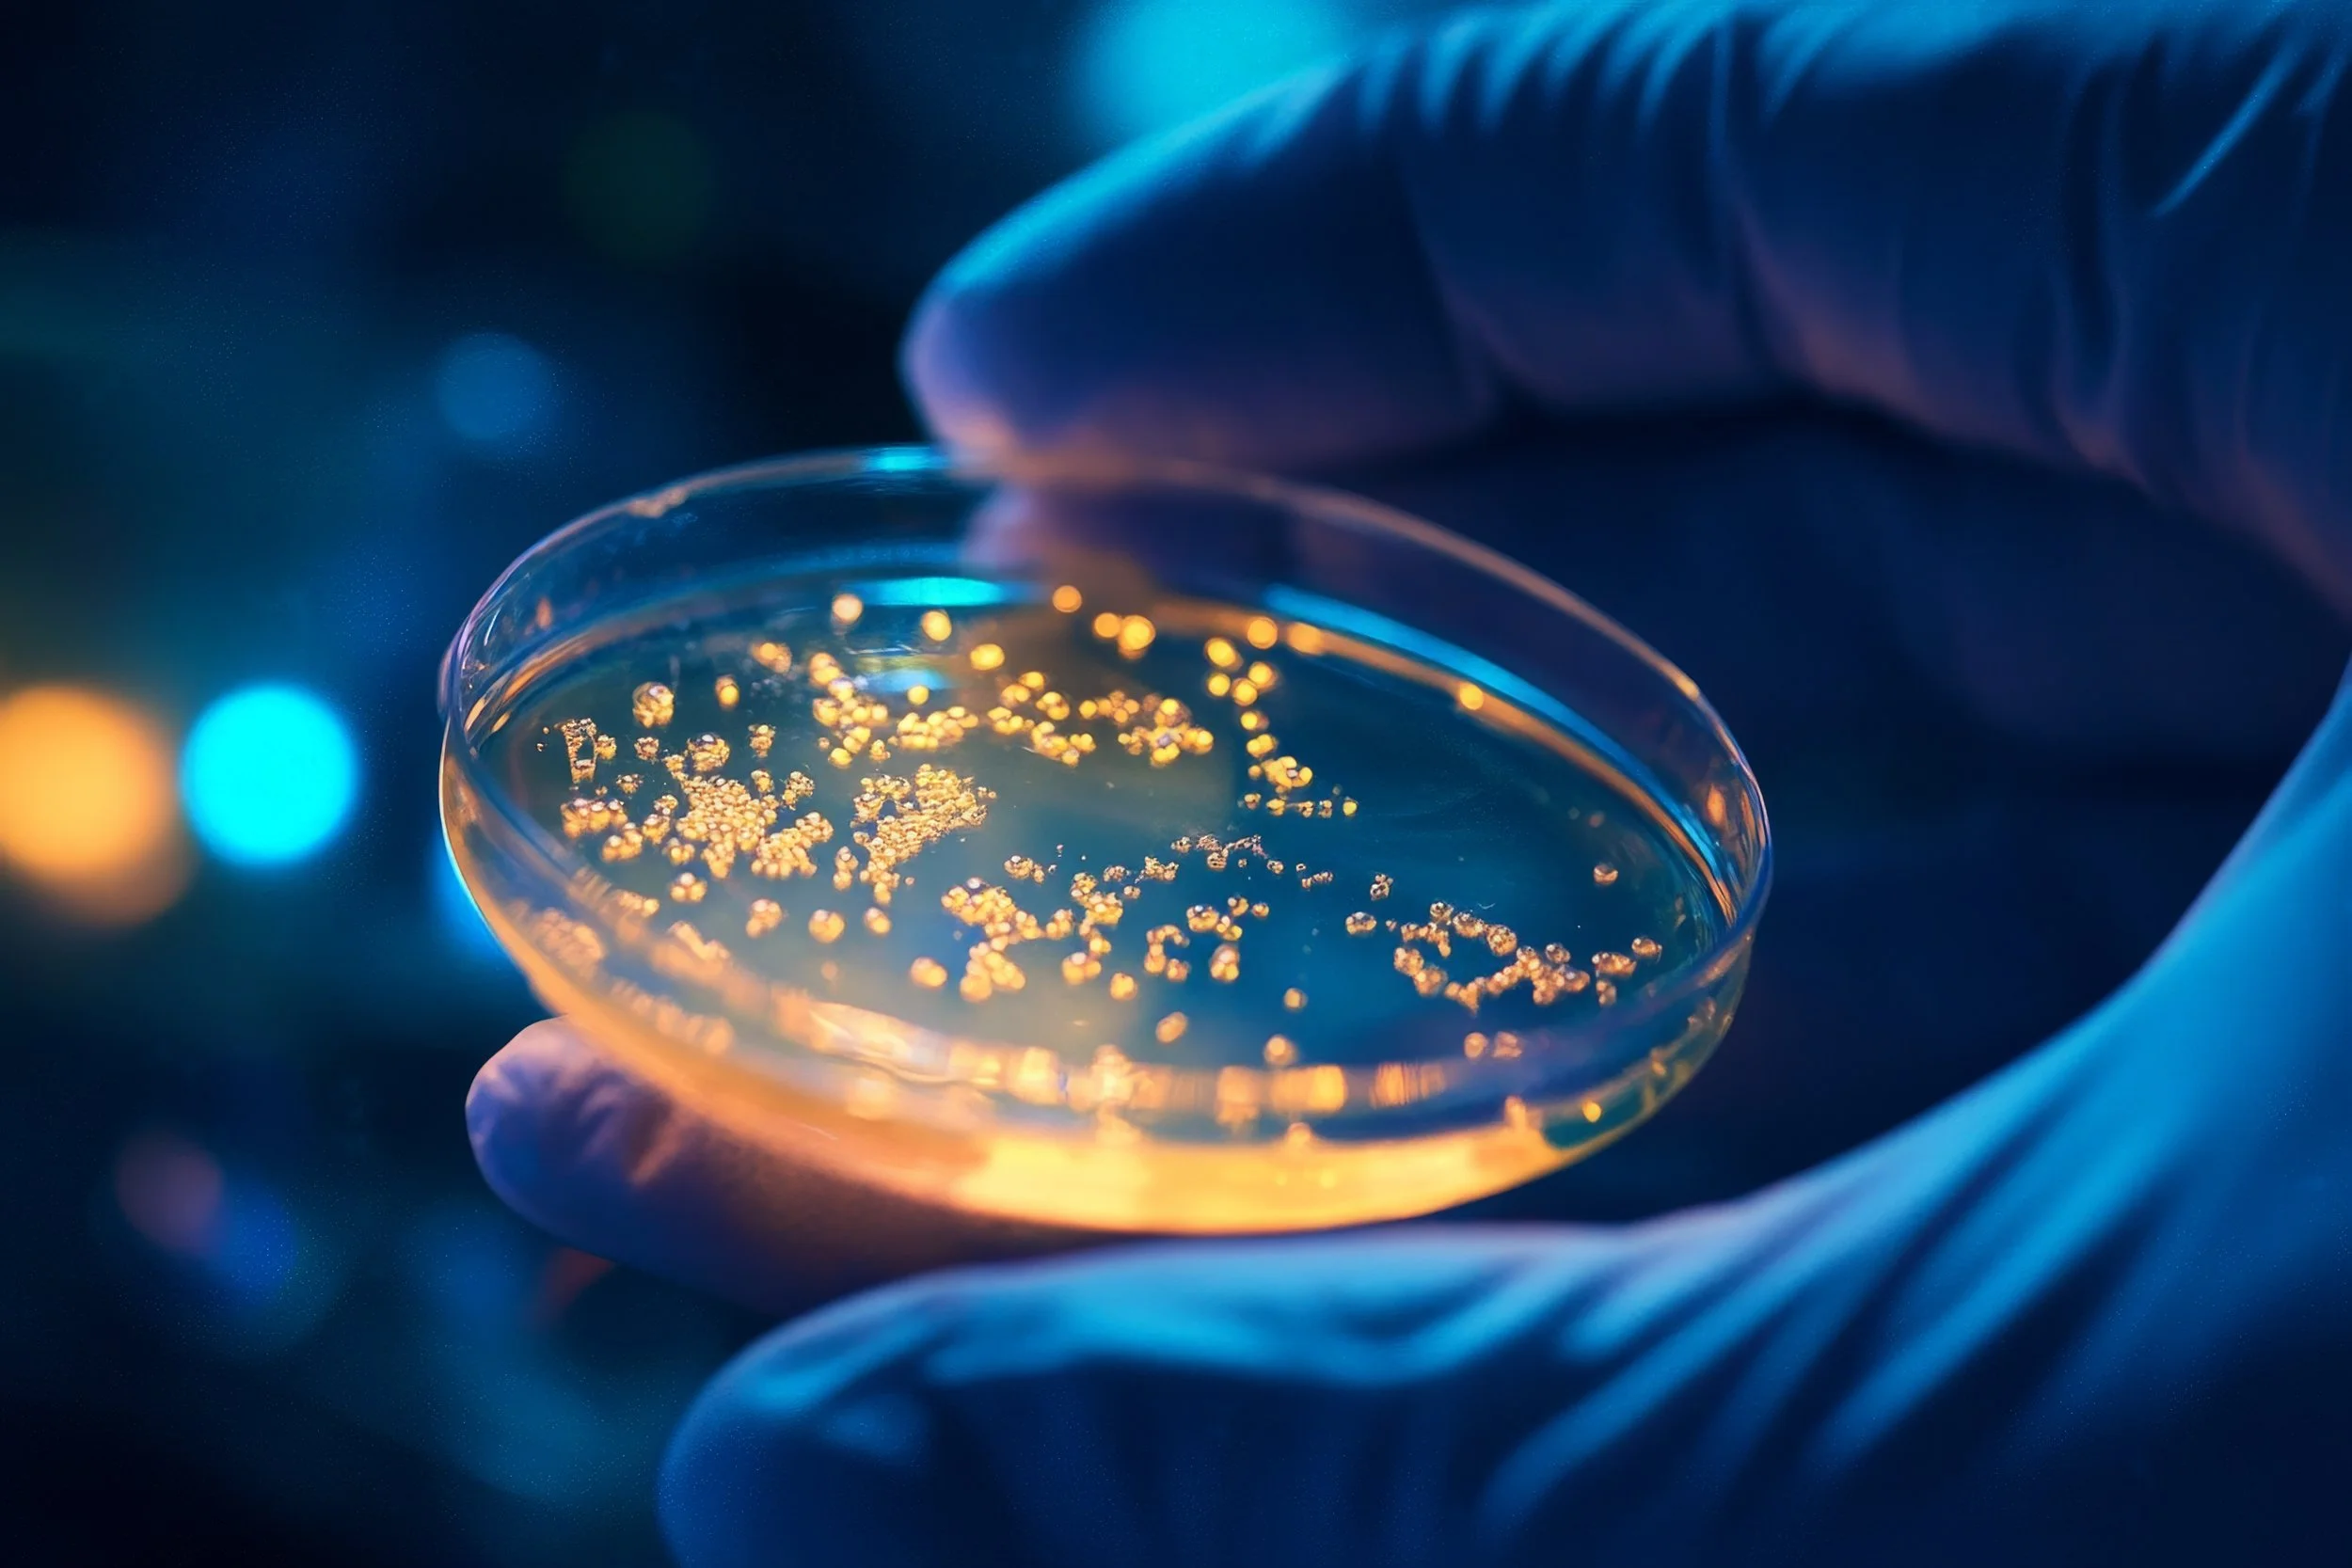

ANTA Biotech is an early-stage start-up
that’s pushing the boundaries of science.
Anta (अन्त) is a Sanskrit word meaning "edge," "frontier," "boundary," and "limit."
Throughout history, edges have been places of discovery. In ancient Sanskrit texts, grāmānte (“gram” + “anta” = “grāmānte”)—"at the edge of the village"—described the boundary between the familiar and the unknown, where explorers took their first steps into uncharted territory.
At ANTA, we bring biology to the edge.
The edge of innovation, where automated technology makes the impossible routine.
The edge of extreme environments, from polar ice to deep ocean.
The edge of space, where the International Space Station orbits.
Wherever science needs to go, we make it possible.
Edge (anta) is not a limitation—it's an invitation.
The edge is where discovery happens.
The edge is where innovation is required.
The edge is where the future is built.
We don't just operate at the edge. We are the edge.
At ANTA, our mission is to develop automated biotools that operate anywhere— from remote field sites on Earth to Space stations in low Earth orbit.
Traditional biology is confined to the lab.
We bring the lab to the edge.
We develop technologies that thrive where traditional tools fail—whether on an orbiting spacecraft, a remote location, in the field, outside the traditional lab, and even inside on the bench. Our innovations in biochemistry and device design, inspired by Space, are reshaping how and where biology can be done.
Your questions,
answered
What is “biology at the edge”?
We have coined the phrase “biology at the edge” to define biological tools that enable immediate and on-demand functionality — like edge compute. Biology at the edge is a union of research and biotechnology at the extreme boundaries of operational environments and technological capabilities. Biology at the edge encompasses advancing scientific understanding in previously inaccessible research domains.
For ANTA, "the edge" has five interconnected meanings:
THE CUTTING EDGE Automated. Miniaturized. Gravity-agnostic. State-of-the-art technology that redefines what's possible.
EDGE COMPUTING Decentralized biological data processing. Analysis at the point of collection, not back in the lab. We ship data, not samples.
THE TACTICAL EDGE
Far-forward deployment. Remote operating bases. Field laboratories. Underserved communities. Where traditional labs can't go, we operate.
THE EDGE OF HABITABILITY
Extreme environments. Deserts. Polar regions. Deep ocean.
At the limits of Earth's livable zones, we enable science.
THE EDGE OF EXPLORATION
Space. The International Space Station. Lunar bases. Mars missions.
We are bringing biology to the frontier.
Why Space?
Space is a unique environment. Decades of research has shown that the conditions of Space, especially weightlessness (commonly known as microgravity), alter gene expression. There is much to be explored and learned. But, the right tools are not available to do this in Space. Developing gravity-agnostic tools will open up the final frontier to a new era of research and discovery. We firmly believe that solving for Space also solves many problems for Earth.
What future-proofed lab tool are you building first?
Engineering gravity-agnostic lab instruments where the same device can function both on Earth and in Space is a “white space problem”. Our first “zero to one” technology aims to automate sequencing in Space.
Why biology at the edge matters.
To allow Space scientists to iterate their research in real time on the ISS (or near-future commercial space stations) with in situ analytical tools.
To allow future missions to the Moon or Mars to be less dependent on Earth and enable advanced research long distances from Earth.
To equip military personnel with diagnostics capabilities against pathogens and bioweapons at the far-forward edge.
To allow researchers studying extremophiles in Antarctica or the deep ocean to collect and analyze samples at the Earth’s edge.
To enable farmers to monitor their crop and livestock health in real-time at the farm’s edge.
To help terrestrial scientists at the lab bench reduce errors and speed up research by automating routine protocols.
We are building the infrastructure for biology beyond boundaries.

Meet the team
ANTA Biotech was founded by scientists and engineers driven by the need for an automated solution. Meet our team of founders, scientists, engineers, and advisors. It takes a global village to bring ideas to life.
Anjali Gupta, PhD MBA Founder & CEO
Gene Yeo, PhD MBA Co-founder & Advisor
Noorsher Ahmed, PhD Co-founder & Advisor
Cassandra Juran, PhD Co-founder & Advisor
Caitriona Brennan, PhD Scientist

Madeline Phelps, BSE Engineer

Dave Laygo, BSE Engineer

Analyne Schroeder, PhD Scientist
John Shoffner
Advisor
Megan Sieffert
Advisor
Chris Mason, PhD
Advisor
Joydeep Goswami, PhD Former Advisor
Our supporters and partners
are key to our success.


















